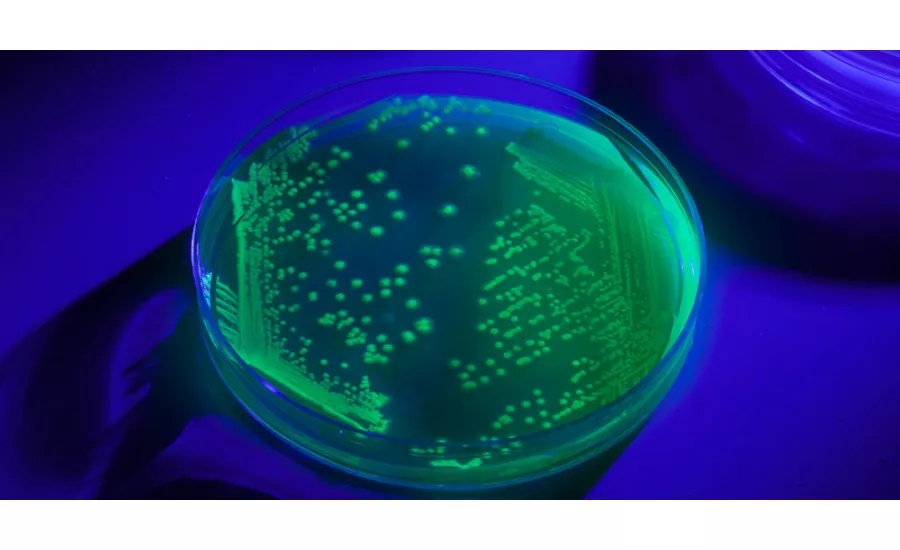

Microbiologics Green Fluorescent Protein Marked Microbial Controls
Microbiologics has announced the expansion of its UV-BioTAG™ line of microbial control strains containing green fluorescent protein (GFP) markers. Designed for food microbiology testing, UV-BioTAG control cultures visibly fluoresce under ultraviolet (UV) light, making them easily distinguishable from naturally occurring microflora and true contamination. Microbiologics launched UV-BioTAG in 2016 to provide a simple yet effective tool for laboratories conducting analyses of food products.
Food manufacturers and processors are routinely testing samples to detect the presence of harmful pathogens such as Escherichia coli, Listeria monocytogenes, and Salmonella enterica before products are distributed for consumption. Laboratories use positive control cultures in their Quality Control (QC) programs to ensure their test methods, materials, and procedures are consistently producing accurate results. In some cases, food samples may inadvertently become cross-contaminated with the laboratory’s QC cultures during processing, leading to false-positive test results. If colonies are recovered from a food sample and they do not fluoresce under UV light, cross-contamination from UV-BioTAG control strains can be instantly ruled out as the cause.
The GFP reporter for UV-BioTAG strains is integrated into the microorganism’s chromosome to provide superior stability, particularly over plasmid-based reporters that may be lost during enrichments designed to recover pathogens from food. For each strain, the GFP reporter is controlled by a strong promoter for highly visible fluorescence, and they are rigorously tested to ensure authenticity, stability, and compatibility with common detection technologies. Microbiologics collaborated with the U.S. Food and Drug Administration to choose the control strains that were developed into its UV-BioTAG product line. The list of new UV-BioTAG strains includes:
- S. enterica subsp. enterica serovar Abaetetuba
- S. enterica subsp. enterica serovar Bispebjerg
- S. enterica subsp. enterica serovar Tranoroa
- S. enterica subsp. enterica serovar Nottingham
- Klebsiella aerogenes
- Yersinia enterocolitica
- Cronobacter sakazakii
- Vibrio cholerae serovar O139
UV-BioTAG is available in two user-friendly formats. The UV-BioTAG Vial Kit includes six individual vials containing a single lyophilized microorganism pellet in each, which are rehydrated in a sterile fluid, such as saline, and then plated on culture media. The UV-BioTAG Swab Kit contains six all-in-one devices featuring a lyophilized microorganism pellet, ampoule of rehydration fluid, and a swab, which allows for direct inoculation of culture media.
Microbiologics | www.microbiologics.com
Looking for quick answers on food safety topics?
Try Ask FSM, our new smart AI search tool.
Ask FSM →







